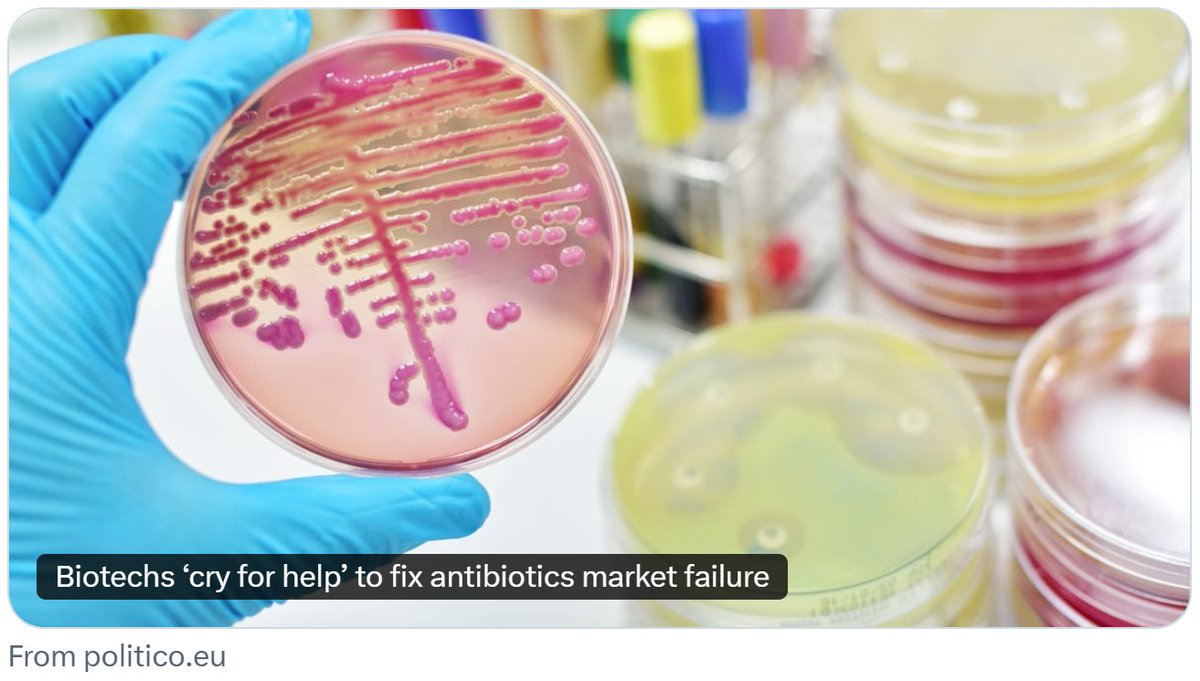

Waksman Institute, Rutgers University
@waksman_inst
Interdisciplinary research institute focused on microbiology, developmental biology, cell biology, structural biology, genetics, and genomics. Founded in 1954.
ID: 1348271546121465862
https://www.waksman.rutgers.edu/ 10-01-2021 14:14:32
646 Tweet
1,1K Followers
779 Following








🧵 Biosafety Flashback '09 The University of Texas Medical Branch (UTMB) Commits Perjury while Trying to Shut Down #FOIA on its Bioweapons Agents Research UTMB Health


harish seshadri Hideki Kakeya, Dr.Eng. In the US, research on Ebola virus research is performed in downtown Boston and on the Galveston sandbar (which periodically is scraped to bare sand by hurricanes).












![Richard H. Ebright (@r_h_ebright) on Twitter photo "[R]esearchers modeled the impact of one hypothetical pan-resistant strain of E. coli on sepsis deaths in the US...The models...showed that sepsis deaths could increase by 18 to 46 times just five years after the introduction of such a strain." "[R]esearchers modeled the impact of one hypothetical pan-resistant strain of E. coli on sepsis deaths in the US...The models...showed that sepsis deaths could increase by 18 to 46 times just five years after the introduction of such a strain."](https://pbs.twimg.com/media/GgyCE3HWcAA4eiD.png)
![Richard H. Ebright (@r_h_ebright) on Twitter photo '[W]e identified 9 highly drug-resistant strains from 4 countries that carried resistance mutations to [rifampin, isoniazide, and] all BPaL/M compounds, thus potentially classifying them as 'totally drug-resistant.'" '[W]e identified 9 highly drug-resistant strains from 4 countries that carried resistance mutations to [rifampin, isoniazide, and] all BPaL/M compounds, thus potentially classifying them as 'totally drug-resistant.'"](https://pbs.twimg.com/media/GhGO4k5XoAArkPQ.png)
![Richard H. Ebright (@r_h_ebright) on Twitter photo "The team...found that nine strains carried resistance mutations to [rifampin, isoniazide, fluoroquinolones, and] all of the BPaL/M drugs. These strains, found in four countries—Belarus, Georgia, India, and South Africa—were classified as 'totally drug-resistant.'" "The team...found that nine strains carried resistance mutations to [rifampin, isoniazide, fluoroquinolones, and] all of the BPaL/M drugs. These strains, found in four countries—Belarus, Georgia, India, and South Africa—were classified as 'totally drug-resistant.'"](https://pbs.twimg.com/media/GhGTPc6WAAArG3N.png)

![Richard H. Ebright (@r_h_ebright) on Twitter photo "[A]ntimicrobial resistance…is one of the major global threats to human health…[T]he current clinical development pipeline contains little innovation with many analogs of the same known antibiotics or not targeting critical pathogens."
revive.gardp.org/how-can-we-clo… "[A]ntimicrobial resistance…is one of the major global threats to human health…[T]he current clinical development pipeline contains little innovation with many analogs of the same known antibiotics or not targeting critical pathogens."
revive.gardp.org/how-can-we-clo…](https://pbs.twimg.com/media/Glco4SaXwAADpZZ.png)
